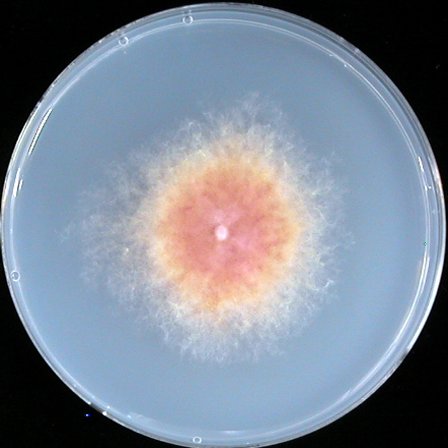

|
| |||||||||||||||||||||||||||||||||||||||||||||||||||||||||||||||||||||||||||||||||||||
 Gene information Gene information |
|||
| Locus | FGSG_07928 | Length | 726 aa |
| Gene Name | GzC2H059 | # Motifs | 2 |
| Family-1 | C2H2 zinc finger | Deletion | Y |
| Family-2 | Parent strain | GZ3639 | |
| Family-3 | Reference | ||
 Primers Primers |
S o u t h e r n b l o t |
 |
|
| name | sequence | ||
| 5F | GCACTCATGTTGTTCTTACTTGTTGC | ||
| 5R | gcacaggtacacttgtttagagGCGGTTGAGGAGCTGTGTTAGGTC | ||
| 3F | ccttcaatatcatcttctgtcgTAAAGCGTACTGAGCTGCTGCGT | ||
| 3R | GAGTGCACTTTCGCTGAGATTACG | ||
| 5N | TTGGTCGGGCAACGCAACTAAC | ||
| 3N | TTTAACCCACACTCCACCACCTACG | ||
| with 5F | GTCTCCCGAGTCGCCTGATTTAT | ||
 Phenotypes Phenotypes |
Wild type | Mutant | |
| Mycelia growth | PDA |  |
 |
| MM |  |
|
|
| Sexual development | Number of perithecia (NP) |  |
 |
| Perithecia maturation (PM) | |||
| Ascospore formation (AF) | No image | No image | |
| Ascospore discharge (AD) | |||
| Conidiation (106) | |||
| Toxin Production | No image | No image | |
| Virulence |  |
 |
|
| Stress responses | |||
| No image | |||